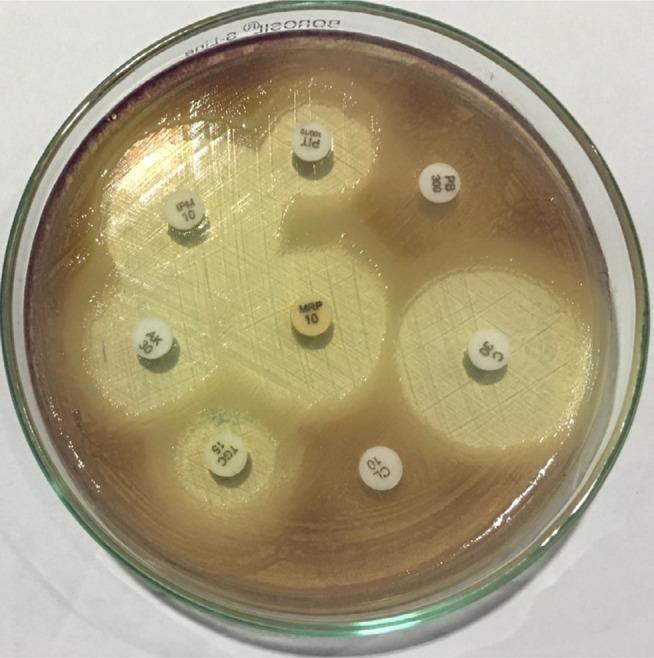
https://cdn.ncbi.nlm.nih.gov/pmc/blobs/466d/5147401/7e5629fc0498/ijgm-9-441Fig5.jpg
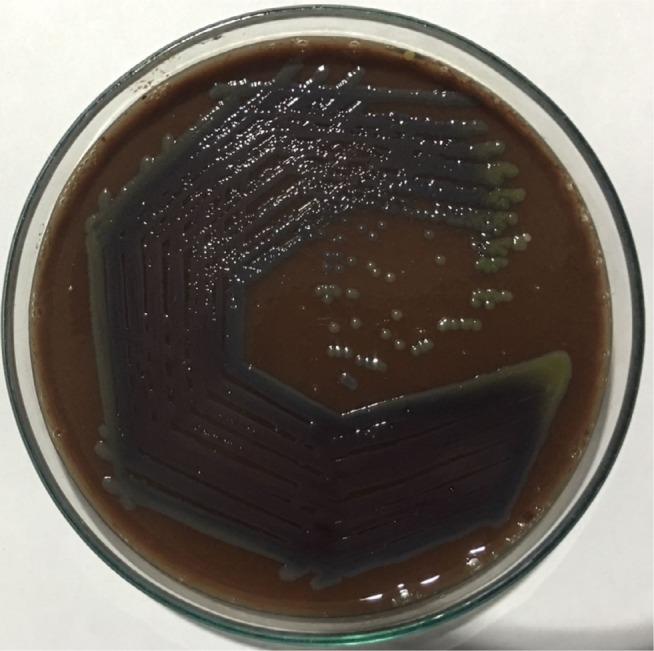
https://cdn.ncbi.nlm.nih.gov/pmc/blobs/466d/5147401/1356ba54f74e/ijgm-9-441Fig1.jpg
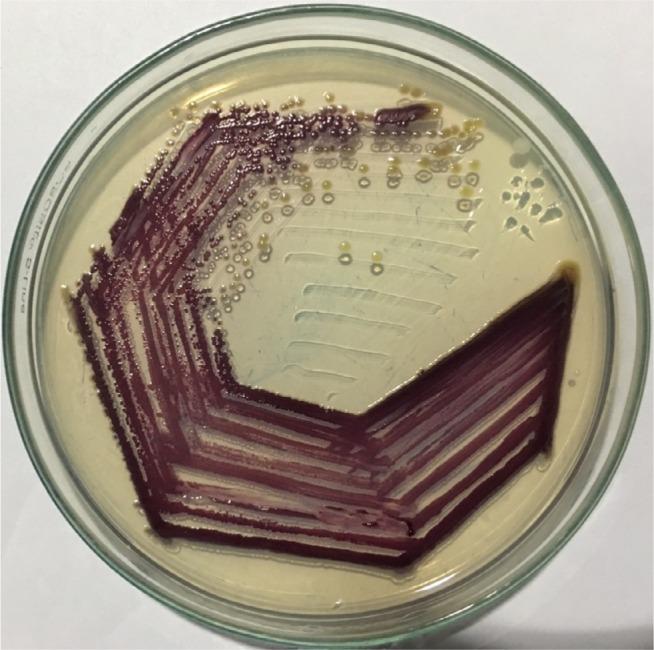
https://cdn.ncbi.nlm.nih.gov/pmc/blobs/466d/5147401/9860857f9645/ijgm-9-441Fig2.jpg

由一种罕见病原体引起的菌血症——尼泊尔的一例病例报告
Bacteremia caused by a rare pathogen - : a case report from Nepal.
作者信息
Parajuli Narayan Prasad, Bhetwal Anjeela, Ghimire Sumitra, Maharjan Anjila, Shakya Shreena, Satyal Deepa, Pandit Roshan, Khanal Puspa Raj
机构信息
Department of Clinical Laboratory Services, Manmohan Memorial Medical College and Teaching Hospital, Kathmandu; Department of Laboratory Medicine, Manmohan Memorial Institute of Health Sciences, Kathmandu, Nepal.
Department of Laboratory Medicine, Manmohan Memorial Institute of Health Sciences, Kathmandu, Nepal.
出版信息
Int J Gen Med. 2016 Dec 5;9:441-446. doi: 10.2147/IJGM.S125183. eCollection 2016.
is a gram negative saprophytic bacterium, prevalent in tropical and subtropical climates. Infections caused by are very uncommon, yet it can cause severe systemic infections with higher mortality when entered into the bloodstream through open wound. A case of symptomatic bacteremia in a woman caused by was identified recently at a tertiary care teaching hospital in Nepal. Timely diagnosis by microbiological methods and rapid administration of antimicrobials led to a successful treatment of this life-threatening infection in this case. From this experience, we suggest to include this bacterium in the differential diagnosis of sepsis, especially when abraded skin is exposed to soil or stagnant water in tropical areas. The precise antimicrobial selection and timely administration should be considered when this infection is suspected.
是一种革兰氏阴性腐生菌,在热带和亚热带气候中普遍存在。由其引起的感染非常罕见,但当通过开放性伤口进入血液时,它可导致严重的全身感染,死亡率较高。最近,在尼泊尔一家三级护理教学医院发现了一例由该菌引起的有症状菌血症的女性病例。通过微生物学方法及时诊断并迅速使用抗菌药物,成功治疗了该例危及生命的感染。从这一经验来看,我们建议在脓毒症的鉴别诊断中纳入这种细菌,尤其是当热带地区有擦伤的皮肤接触到土壤或积水时。当怀疑有这种感染时,应考虑精确选择抗菌药物并及时给药。